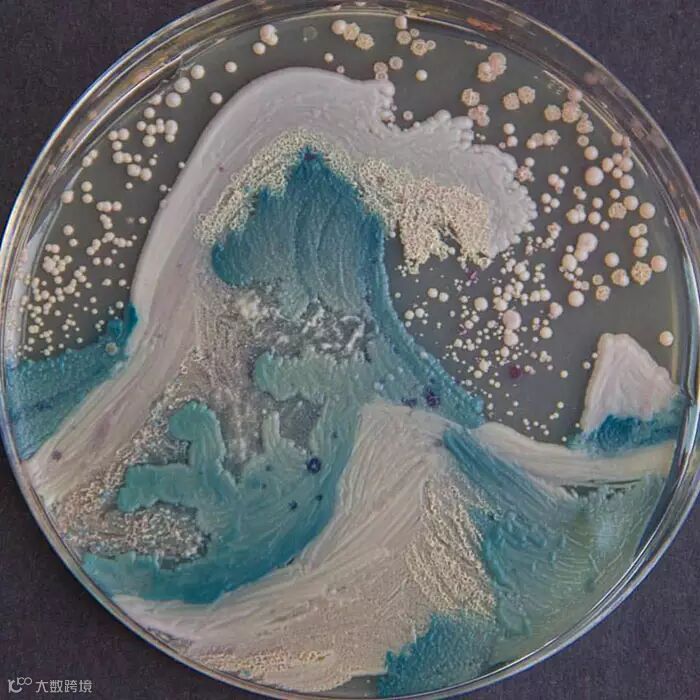

当年文理科分道扬镳,
于是有了函数曲线与经纬线的区别。
然而,这个公式从来是骗文科生的玩意儿,
真相是……
牛逼的理科生也能兼长文学艺术,
文学艺术大亨却很难通透理科生的世界……
梵高,《星月夜》
变形杆菌、鲍曼不动杆菌、粪肠球菌、肺炎克雷伯氏菌

喏,一群来自世界各地的生物学家不好好在实验室里做实验,偏偏要举办什么国际琼脂艺术挑战赛,用我们看都看不见的细菌和微生物培养出了一幅幅美丽的艺术作品,这逼格真高……
他们用自带色儿的微生物在琼脂培养皿这块画布上施粉涂色,还能设定条件(如光照)以改变微生物性状,想变啥就变啥,想变啥色儿就变啥色儿。(不明觉厉的旁友们,可以忽略以下“xxx菌”。)
盛开的太阳花
志贺氏杆菌、沙门氏菌

波涛汹涌
白色念珠菌,光滑念珠菌,近平滑念珠菌
丰收的季节
酵母菌

纽约生态地图
大肠杆菌

夜空
天蓝色链霉菌

细胞之间的活动

神经元

蘑菇

细胞群

水母

手印

图片来自boredpanda


